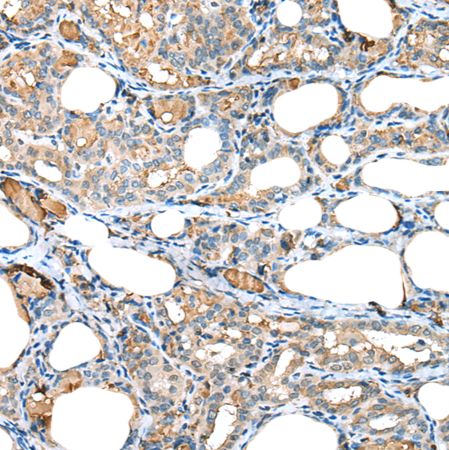
兔抗RPL35A多克隆抗体

相关产品推荐更多 >
万千商家帮你免费找货
0 人在求购买到急需产品
- 详细信息
- 技术资料
- 形态:
液体
- 保存条件:
冷冻(-20℃)避光
- 克隆性:
多克隆
- 保质期:
一年
- 抗原来源:
RPL35A
- 库存:
200
- 供应商:
上海酶联生物科技有限公司
- 宿主:
Rabbit
- 应用范围:
仅供科研使用
- 抗体英文名:
Anti-RPL35Arabbitpolyclonalantibody
- 抗体名:
兔抗RPL35A多克隆抗体
- 规格:
100ul/200ul/25ul
| 规格: | 100ul | 产品价格: | ¥1560.0 |
|---|---|---|---|
| 规格: | 200ul | 产品价格: | ¥2500.0 |
| 规格: | 25ul | 产品价格: | ¥420.0 |
中文名称:中文名称: 兔抗RPL35A多克隆抗体
英文名称:Anti-RPL35Arabbitpolyclonalantibody
别名:DBA5;L35A
相关类别:一抗
储存:冷冻(-20℃)
宿主:Rabbit
抗原:RPL35A
反应种属:Human,Mouse,Rat
标记物:Unconjugate
克隆类型:rabbitpolyclonal
技术规格
英文名称:Anti-RPL35Arabbitpolyclonalantibody
别名:DBA5;L35A
相关类别:一抗
储存:冷冻(-20℃)
宿主:Rabbit
抗原:RPL35A
反应种属:Human,Mouse,Rat
标记物:Unconjugate
克隆类型:rabbitpolyclonal
技术规格
| Background: | Ribosomes,theorganellesthatcatalyzeproteinsynthesis,consist ofasmall40Ssubunitandalarge60Ssubunit.Togetherthesesubu nitsarecomposedof4RNAspeciesandapproximately80structura llydistinctproteins.Thisgeneencodesaribosomalproteinthatisac omponentofthe60Ssubunit.TheproteinbelongstotheL35AEfam ilyofribosomalproteins.Itislocatedinthecytoplasm.Theratprotei nhasbeenshowntobindtobothinitiatorandelongatortRNAs,andt hus,itislocatedatthePsite,orPandAsites,oftheribosome. |
| Applications: | ELISA,IHC |
| Nameofantibody: | RPL35A |
| Immunogen: | Fulllengthfusionprotein |
| Fullname: | ribosomalproteinL35a |
| Synonyms: | DBA5;L35A |
| SwissProt: | P18077 |
| ELISARecommendeddilution: | 5000-10000 |
| IHCpositivecontrol: | Humanthyroidcancer |
| IHCRecommenddilution: | 25-100 |
风险提示:丁香通仅作为第三方平台,为商家信息发布提供平台空间。用户咨询产品时请注意保护个人信息及财产安全,合理判断,谨慎选购商品,商家和用户对交易行为负责。对于医疗器械类产品,请先查证核实企业经营资质和医疗器械产品注册证情况。
技术资料兔抗RPL35A多克隆抗体
¥420 - 2500